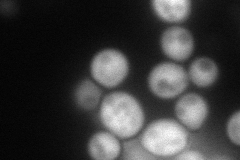
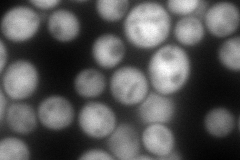
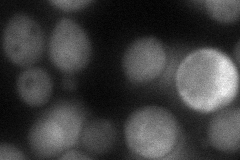

View description
Putative S-adenosylmethionine-dependent methyltransferase; mediates cantharidin resistance
Localization:
Intensity:
Fold change:
Significance:
-
C’ GFP library in SD

below threshold15.84 -
N' NOP1pr-GFP in SD
cytosol119.691 -
N' TEF2pr-mCherry in SD
cytosol246.607 -
N' NATIVEpr-GFP in SD

below threshold22.4721 -
N' TEF2pr-VC and Cyto-VN in SD
cytosol64.6701 -
C’ GFP library in SD+DTT

cytosol16.971.07No -
C’ GFP library in SD+H2O2

cytosol17.291.09No -
C’ GFP library in Starvation Media

cytosol17.781.12No -
C’ GFP library on the background of Pup2-DaMP

below threshold -
C’ GFP library on the background of CCT mutant

below threshold18.24341.1511No
